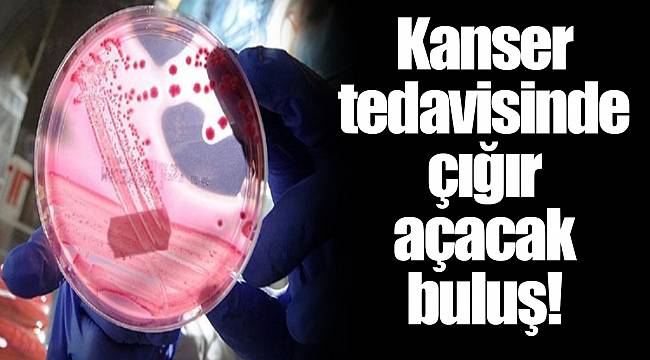
Kanser tedavisinde çığır açacak buluş!

Kanser tedavisinde çığır açacak buluş!
Belçikalı araştırmacılar, kanserin metastaz yapmasına yol açan tümör hücrelerini belirledi. Yapılan buluşla hastalığın tedavisinin kesinlik derecesinin artması umudu doğdu.
Yayınlanma :
23.04.2018 19:40

Özgür Brüksel Üniversitesi (ULB), Katolik Leuven Üniversitesi ve Erasmus Hastanesinden 25 doktor, araştırmayı Avrupa Birliği (AB) fonlarıyla cilt ve göğüs kanserini temel alarak yaptı.
Prof. Dr. Cedric Blanpain'in yönettiği araştırmada bilim adamları, kanserin farklı evrelerindeki hücreleri inceledi ve kötü huylu olanları 6 ayrı kategoriye ayırdı.
KANSER TEDAVİSİNDE ÇIĞIR AÇACAK
Tümör hücrelerinin genetik yapısını inceleyen araştırmacılar, bilinenin aksine bu hücrelerin birbirleriyle aynı olmadığını, kanserin köken aldığı organın dışına çıkarak diğer dokulara yayılmasına neden olan kötü huylu hücrelerin bazı farklılıklar gösterdiğini tespit etti.
Araştırmada elde edilen sonuçların, kanser tedavisini kesinlik derecesini artırabileceğine, metastaza yol açan hücrenin belirlenmesiyle tedavide hedefin daha belirgin hale geleceğine işaret edildi.
"Nature" dergisinde yayımlanan araştırmanın, kanser tedavisinde çığır açabileceği vurgulandı
Yorum Yazma Kuralları
Lütfen yorum yaparken veya bir yorumu yanıtlarken aşağıda yer alan yorum yazma kurallarına dikkat ediniz.
Türkiye Cumhuriyeti yasalarına aykırı, suç veya suçluyu övme amaçlı yorumlar yapmayınız.
Küfür, argo, hakaret içerikli, nefret uyandıracak veya nefreti körükleyecek yorumlar yapmayınız.
Irkçı, cinsiyetçi, kişilik haklarını zedeleyen, taciz amaçlı veya saldırgan ifadeler kullanmayınız.
Türkçe imla kurallarına ve noktalama işaretlerine uygun cümleler kurmaya özen gösteriniz.
Yorumunuzu tamamı büyük harflerden oluşacak şekilde yazmayınız.
Gizli veya açık biçimde reklam, tanıtım amaçlı yorumlar yapmayınız.
Kendinizin veya bir başkasının kişisel bilgilerini paylaşmayınız.
Yorumlarınızın hukuki sorumluluğunu üstlendiğinizi, talep edilmesi halinde bilgilerinizin yetkili makamlarla paylaşılacağını unutmayınız.










Yorumlar
Kalan Karakter: